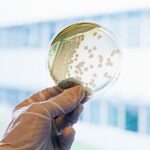

Um grupo de 12 cientistas brasileiros e internacionais prepara o envio de uma carta ao governo federal ainda este mês, solicitando a suspensão imediata do abate de jumentos no país. O alerta destaca o risco de extinção iminente da espécie, simbólica na história rural brasileira, com uma queda de 94% na população desde 1999, passando de 1,37 milhão para apenas 78 mil indivíduos. A iniciativa surgiu no III Workshop Internacional Jumentos do Brasil: Futuro Sustentável, realizado em junho em Maceió, e resultou em um documento com dez razões para o fim da prática, publicado em agosto.
O documento será encaminhado a órgãos como o Ministério Público Federal, Ministério da Casa Civil, Secretaria Geral da Presidência, Ministério da Saúde, Ministério da Agricultura e Ministério do Meio Ambiente, além do Ministério Público da Bahia e de outros estados nordestinos. Entre os argumentos, destacam-se o valor genético único do jumento nordestino, sua relevância ecológica no Semiárido, riscos sanitários associados ao abate e implicações sociais, incluindo denúncias de trabalho infantil e condições análogas à escravidão. Os cientistas também apontam o impacto negativo na imagem do agronegócio brasileiro.
A maior parte dos jumentos abatidos é exportada para a China, onde as peles são usadas na produção de ejiao, um colágeno vendido como elixir rejuvenescedor. Entre 2018 e 2024, pelo menos 248 mil animais foram mortos, concentrados na Bahia, o único estado com frigoríficos autorizados pelo Serviço de Inspeção Federal. A prática persiste sem dados atualizados sobre a população remanescente, o que agrava a crise, segundo os especialistas.
Professores como Adroaldo Zanella, da Faculdade de Medicina Veterinária e Zootecnia da USP, enfatizam a urgência de medidas, destacando o papel cultural e econômico do jumento no Nordeste. Pierre Escodro, da Universidade Federal de Alagoas, critica a posição do Brasil na cadeia internacional de exploração, defendendo alinhamento com práticas de outros países do sul global. Roberto Arruda de Souza Lima, também da USP, menciona alternativas como a fermentação de precisão para produzir colágeno sem exploração animal, vista como estratégica economicamente e ambientalmente.
A campanha é liderada pela organização internacional The Donkey Sanctuary, em parceria com universidades e ONGs brasileiras. A coordenadora no país, Patricia Tatemoto, reforça a oportunidade para o governo proteger a espécie, que poderia viver livre ou como animal de companhia. No âmbito legislativo, o Projeto de Lei 2.387/2022 tramita no Congresso Nacional desde 2022, propondo a proibição do abate, com pareceres favoráveis em comissões, mas aguardando votação na Comissão de Constituição e Justiça.
Na Bahia, o Projeto de Lei 24.465/2022 avança com resistências, aprovado na Comissão de Constituição e Justiça da Assembleia Legislativa, mas com parecer contrário na Comissão de Agricultura devido a possíveis impactos econômicos. Os cientistas invocam a Constituição Federal de 1988, que obriga a proteção da fauna e proíbe práticas que levem à extinção ou crueldade animal.
Diante da falta de informações precisas sobre população, reprodução e condições sanitárias, o grupo pede a suspensão do abate até a realização de estudos atualizados. A mobilização busca alinhar políticas públicas com evidências científicas, evitando uma perda irreversível para a biodiversidade e a cultura nacional.